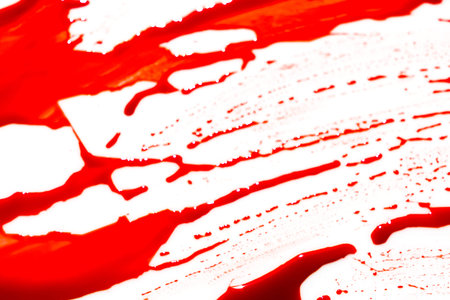
Halloween concept : Blood splatter on white backgroundの写真素材

写真素材 - Halloween concept : Blood splatter on white background
キーワード
- abstract
- background
- black
- blood
- brush
- burst
- collection
- color
- creative
- death
- decoration
- design
- dirty
- drawing
- dribble
- drip
- drop
- dry
- dye
- element
- explosion
- grunge
- halloween
- horror
- ink
- isolated
- liquid
- macabre
- natural
- pack
- paint
- pattern
- red
- scary
- set
- shape
- splash
- splat
- splatter
- spot
- spray
- stain
- texture
- wall
- white
類似作品
Drops of blood ...
Realistic blood...
glass with bloo...
Bloody in sink ...
Lettering in bl...
Fresh red blood...
Blood
A blood on the ...
Red blood/ink s...
Realistic blood...
close-up shot o...
Blood draining ...
Drops frozen mi...
close-up shot o...
Splashes of blo...
Halloween conce...
Drops of blood ...
Drop of blood f...
Realistic effec...
Close up shot o...
Bloody nails on...
red liquid is s...
Dripping blood ...
Christian cross...
blood stains on...
Bloody hallowee...
Drops of blood ...
Red painted spl...
A blood spatter...
close-up shot o...
Bloody in sink ...
set 8. blood dr...
Blood splatter ...
Drops of blood ...
Top view of blo...
Abstract blood ...
red paint on a ...
Drops of blood ...
Blood splashes ...
Fresh red blood...
close-up shot o...
Abstract bloods...
Splatter of red...
Red blood fount...
Drops of blood ...
close up of a d...
Blood draining ...
Blood Dripping
abstract creati...